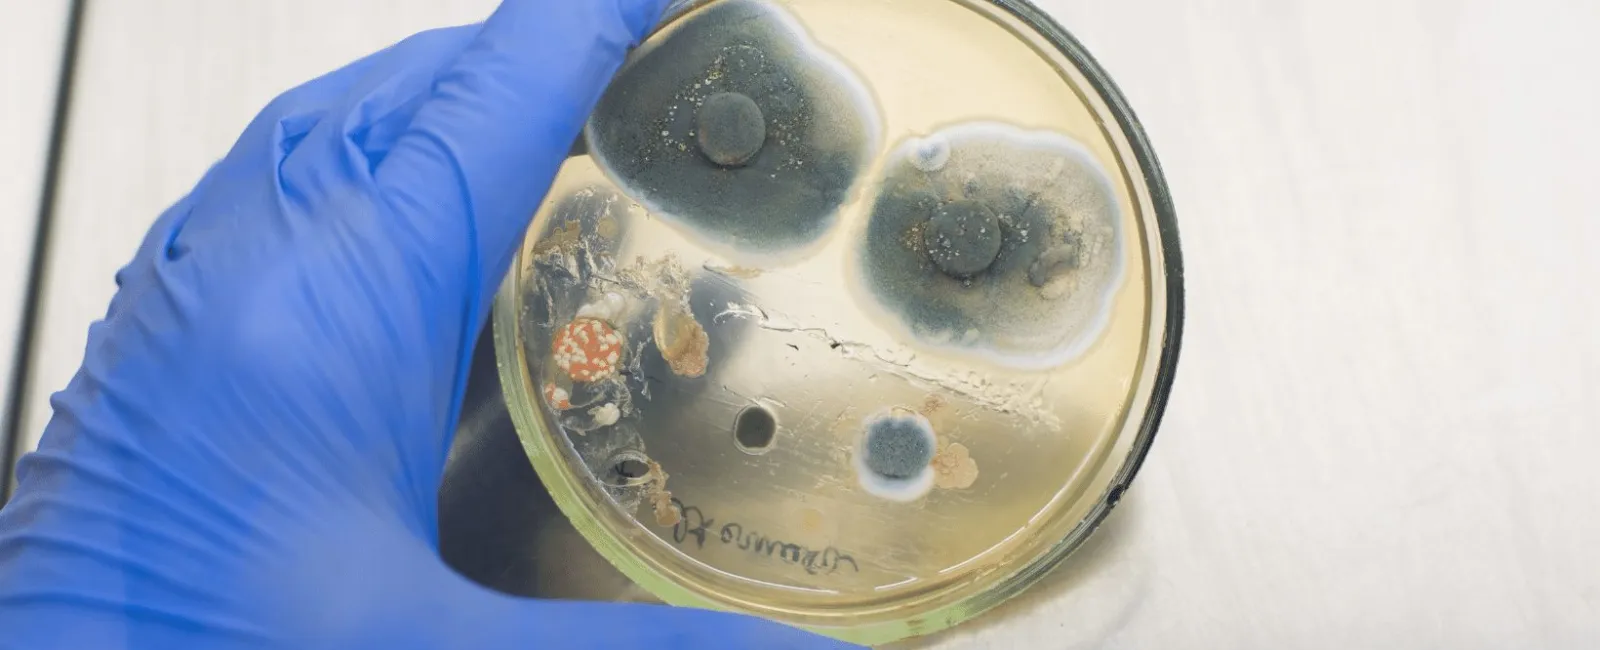
Why Do I Need Mold Testing in My Property?

We get asked this question a lot, "Do I need a mold test?"
The answer most of the time is no. If mold is visible and you know where the problem is, a mold test is usually not necessary. If this is the case, knowing the type of mold is irrelevant and hiring mold removal experts, such as Mold Medics is the way to go.
However, mold testing can be helpful even if it is not necessary, and luckily, Mold Medics does mold testing too! You may be asking yourself when and why you would need a mold test then? We have got you covered! We outlined some of the reasons why you would need mold testing in your property below.
Reasons Why You Would Need a Mold Testing In Your Property
If your property smells musty but you don't see any visible mold, mold testing could be helpful to determine if there actually is mold and where the mold is located. Sometimes mold grows in places that you can't see because of plumbing leaks or water issues. This can occur behind walls, under carpeting, inside ceiling tiles, etc. If you suspect that your property has mold but there is no visible mold, a mold test can help determine the problem and the best course of action.
Mold has adverse effects on your property and your health, so it is important to get mold testing if you smell mold but can't see it. If you are experiencing health problems, such as headaches or sneezing, that you cannot exactly pin-point, you may have mold in your property. In fact, there are many studies that show a strong link between mold and sickness.
Mold testing can help determine the extent of the mold problem in your property. Say you have mold in your basement and you are experiencing allergies or problems due to the air quality, then a mold test can determine the extent of the problem. A test would be able to tell you if the mold in the basement is impacting the air quality throughout your property and how bad the mold problem really is.
You may need a mold test post mold removal to make sure the previous problem has been addressed and mold levels are safe in your home. Mold testing post-service can give you peace of mind and make you feel more comfortable. Not only will this determine if mold is successfully removed from your property, it will help determine if there are any other areas in your home that still need mold remediation. You would be able to address the problem before the mold spreads.
How Mold Medics Can Help
Accurate and reliable mold inspection and testing is critical to keep the air in your home clean and healthy. Our team of experts are trained and certified by the American Council for Accredited Certification (ACAC) to educate our customers while performing high caliber mold testing. Our tests will determine if mold levels are elevated and what types of mold are in the environment. As a part of mold testing, we do air sampling.
In the mold world, the problem isn't what you see, it's what you breathe!
At Mold Medics, our testing services include:
- An in-home inspection of potential problem areas
- Drawing measured air samples from areas of concern while recording the data to ensure accuracy for interpretation
- Drawing an environmental control sample for comparison
- Including pictures and a chain of custody form to be sent for analysis by an independent laboratory
- Providing swab/tape-lift sampling upon request for potential mold identification
- Interpreting laboratory results for mold remediation without scare tactics
Whether you know you want to get a mold test in your property or you are unsure if a mold test is the best route, contact us today to get a free quote! Once you submit our online form, the Mold Medics team will reach out to schedule a free appointment to evaluate and assess your potential mold problem. Once the mold issue is diagnosed, we get to work on making your home healthy again.
We understand that our customers may not feel comfortable with an in-home inspection due to COVID-19. For that reason, we can now assess your home via real-time video. By utilizing video calling technology, we accurately assess the situation and answer all your questions while maintaining social distancing from you and your family. Learn more about virtual mold assessments here.